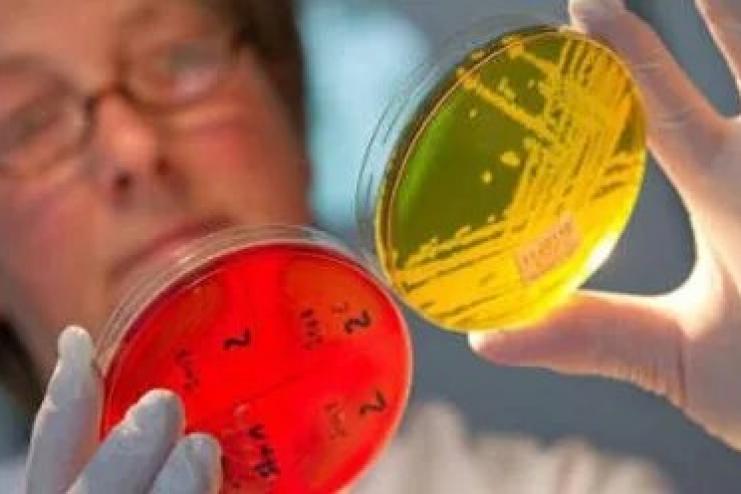

Детсад в Одесской области, где отравились дети, закрыли - подозревают золотистый стафилококк
Детский сад №12 в городе Черноморск временно приостановил работу - количество детей, отравившихся выросло.
В городе Черноморск Одесской области до выяснения всех обстоятельств прекратил работу детский сад №12 "Снегурочка". Количество заболевших детей возросло до восьми. Напомним, ранее сообщалось, что шестеро детей отравились в детском саду в Одесской области.
Как сообщает ИТ-3 со ссылкой на начальницу отдела образования горсовета Наталью Вороненко, на прошлой неделе в больницу попали шестеро воспитанников детского сада «Снегурочка». Однако, у них отрицательные результаты — бактерии золотистого стафилококка не обнаружены.
Также медики взяли анализы на носитель потогонного стафилококка у некоторых сотрудников. Результаты у помощника воспитателя, помощника повара и кладовщика — пока неизвестны. Но они уже отстранены от работы.
По словам начальницы отдела образования, точных результатов анализов пока нет. Однако, по всем симптомам — это золотистый стафилококк.
✅ Стань частью сообщества "Угол Обзора" в facebook и пригласи друзей!
"Угол обзора" ближе к читателю!
Все новости Бессарабии и Украины здесь и сейчас:
✅ Кратко и по сути. Подписывайтесь на наш Telegram-канал
✅ Поддержи нас в Instagram